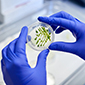

Hurrengo arloetan egiten dugu lan
Laguntzak eta tramiteak
Dirulaguntzak
- Aurkezteko epea zabalik
(2026/07/04 - 2026/10/15)- Izapidetze elektronikoa
- Aurkezteko epea zabalik
(2026/07/02 - 2026/08/01)- Izapidetze elektronikoa
- Aurkezteko epea zabalik
(2026/07/02 - 2026/08/01)- Izapidetze elektronikoa
- Aurkezteko epea zabalik
(2026/07/01 - 2026/09/30)- Izapidetze elektronikoa
- Aurkezteko epea zabalik
(2026/07/01 - 2026/09/30)- Izapidetze elektronikoa
- Aurkezteko epea zabalik
(2026/06/27 - 2026/07/27)- Izapidetze elektronikoa
Lizentziak eta baimenak
Deialdiak
Estatistika
Lehen Sektoreko eta Nekazal Elikagai Industriako Estatistika guztiak, ofizialak eta ez ofizialak.
Argitalpenak eta dokumentazioa
Arloarekin harremana duten liburuak, aldizkariak, buletinak, txostenak, memoriak, katalogoak eta eskuliburuak.
 Euskadiko Nekazaritza, Elikadura eta Gastronomiari buruzko Legearen aurreproiektua jendaurrean jartzea
Euskadiko Nekazaritza, Elikadura eta Gastronomiari buruzko Legearen aurreproiektua jendaurrean jartzea Eusko Jaurlaritzak 2025eko NPBren ordainketak amaitu ditu, euskal lehen sektoreari 42 milioi euro baino gehiago ordainduta
Eusko Jaurlaritzak 2025eko NPBren ordainketak amaitu ditu, euskal lehen sektoreari 42 milioi euro baino gehiago ordainduta Euskadiko Elikagaien Industriarako Sustapen Plana 2027
Euskadiko Elikagaien Industriarako Sustapen Plana 2027 Nekazaritza, Abeltzaintza eta Basogintza
Nekazaritza, Abeltzaintza eta Basogintza Landa Garapena eta Europar Politika
Landa Garapena eta Europar Politika Arrantza eta Akuikultura
Arrantza eta Akuikultura Portuak, Itsas Gaiak eta Itsasertza
Portuak, Itsas Gaiak eta Itsasertza Elikagaien Politika eta Industria
Elikagaien Politika eta Industria Elikagaien Kalitatea eta Sustapena
Elikagaien Kalitatea eta Sustapena Berrikuntza
Berrikuntza Neiker
Neiker Hazi
Hazi Elika
Elika